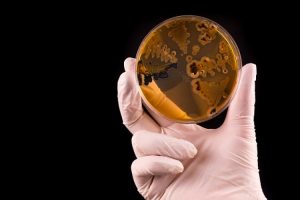

Salmonela ubija rak
Bakterija salmonela, koja izaziva trovanje hranom, može da ubije ćelije raka, ostavljajući nedirnute zdrave ćelije, rekli su naučnici. Naučnici sa Univerziteta Čonam u Južnoj Koreji razvili su genetski izmijenjen oblik salmonele koji napada ćelije tumora, ali ostavlja zdrave. Ovo je posljednji u nizu pomaka u okviru novog polja tretiranja raka […]




